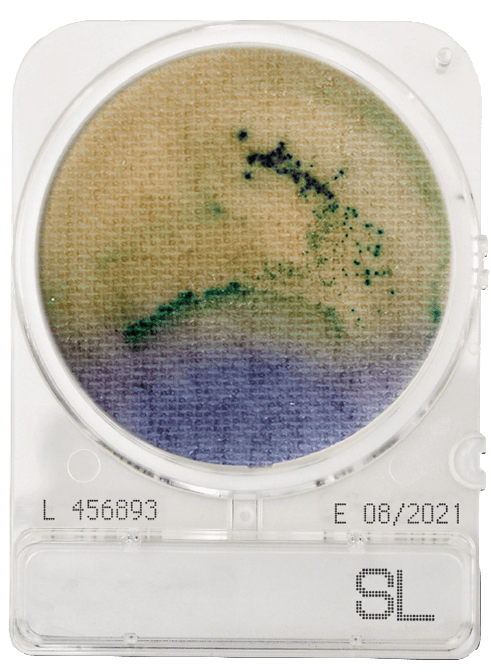

At a very high Salmonella concentration, the entire salmonella test plate will become yellow with dense plaques of green/black colonies.
CompactDry SL is a dehydrated selective chromogenic media for Salmonella identification. Detection of Salmonella contamination is critical in the food manufacturing process. CompactDry SL detects Salmonella using a 20-24 hours pre-enrichment step followed by incubation at 41-43°C on the CompactDry SL plate.
CompactDry SL uses a combination of different test principles based on bacterial motility and specific chromogenic coloration.
The first indication of the presence of Salmonella is a yellowing of the blue/purple media caused by Salmonella lysine decarboxylase. As the motile Salmonella spread across the plate, the blue/purple plate also becomes yellow, mirroring the Salmonella motility.
Subsequent and/or concomitant greening of the colony is caused by decomposition of chromogenic substrate by a specific Salmonella enzyme. Black/green colonies are generated by the hydrogen sulphide producing Salmonella.
To interpret Salmonella positive results, you will observe a spread of black/green individual or fused colonies and a colour change of the CompactDry SL Salmonella selective chromogenic media from the normal blue/purple colour to yellow.